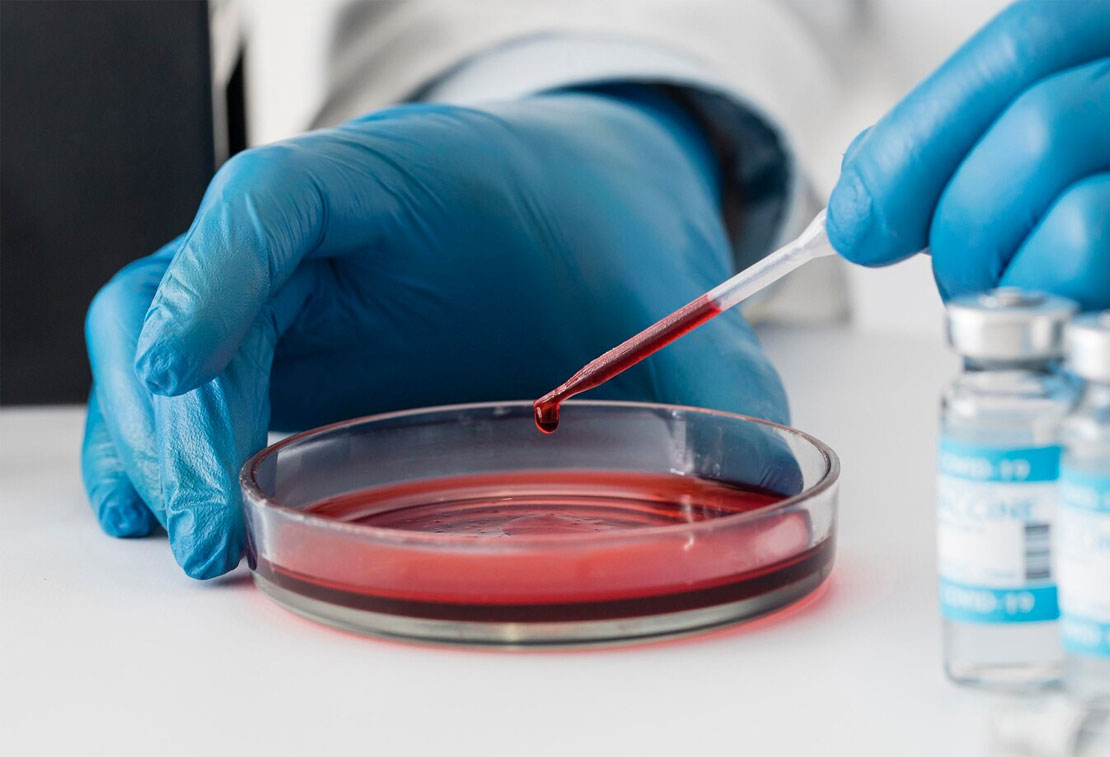

Validité d'une ordonnance pour une prise de sang : durée et remboursement
Vous avez retrouvé une ancienne prescription médicale au fond d’un tiroir et vous vous demandez si vous pouvez encore l’utiliser ? Contrairement aux médicaments, la durée de validité d’une ordonnance pour une prise de sang obéit à des règles souples mais précises. Entre le cadre légal, les délais de remboursement de la Sécurité Sociale et la nécessité médicale, voici tout ce qu’il faut savoir avant de vous rendre au laboratoire.
Quelle est la durée de validité d’une ordonnance pour une prise de sang ?
Officiellement, il n’existe aucune date limite de validité pour une ordonnance de prise de sang en France. Toutefois, pour garantir le remboursement par l’Assurance Maladie et la pertinence du diagnostic, il est fortement recommandé de réaliser l’examen dans un délai d’un an maximum après la date de prescription.
Y a-t-il une date limite légale pour faire sa prise de sang ?
Si vous êtes habitué à aller en pharmacie, vous savez que la délivrance de médicaments est strictement encadrée (généralement 3 mois). Pour les examens biologiques, c’est différent.
Le Code de la Santé Publique ne fixe aucun délai de péremption légal pour une ordonnance d’analyse médicale. En théorie, une ordonnance datant de plusieurs années est toujours valable juridiquement. Pour en savoir plus sur les règles générales de validité des documents médicaux, vous pouvez contacter votre caisse primaire d’assurance maladie pour obtenir des informations spécifiques à votre situation. (cpam)
Cependant, cette validité « théorique » se heurte à deux réalités pratiques : la pertinence médicale et la prise en charge financière.
Pourquoi les laboratoires peuvent-ils refuser une ordonnance ancienne ?
Même si l’ordonnance est légalement valide, le biologiste médical peut émettre des réserves. Voici pourquoi il est risqué d’attendre.
1. Le remboursement par l’Assurance Maladie
C’est le point de blocage le plus fréquent. Les Caisses Primaires d’Assurance Maladie (CPAM) appliquent une règle de gestion tacite : un acte prescrit il y a trop longtemps n’est plus considéré comme médicalement justifié.
La pratique : La majorité des laboratoires acceptent le tiers-payant (dispense d’avance de frais) pour les ordonnances de moins d’un an.
Le risque financier : Au-delà d’un an, le laboratoire risque un rejet de facturation. Il pourra donc vous demander de régler la totalité de la somme à l’avance. Le remboursement ultérieur par la Sécurité Sociale n’est alors pas garanti.
2. La fiabilité du diagnostic médical
Une prise de sang est une « photographie » instantanée de votre métabolisme. Les résultats servent à poser un diagnostic à un moment précis.
Évolution biologique : Votre taux de cholestérol, de fer ou votre TSH peuvent changer en quelques mois.
Infection : Si l’ordonnance visait à identifier une inflammation (CRP), attendre rend l’analyse obsolète.
Utiliser une vieille ordonnance risque de fausser l’interprétation de votre médecin. [ Comment bien lire et comprendre ses résultats de prise de sang ?]
Ordonnance renouvelable et ALD : Les cas particuliers
Certaines situations permettent d’étendre la validité ou d’utiliser la prescription plusieurs fois.
La mention « À renouveler »
Si votre médecin a inscrit la mention « À renouveler X fois » ou « Renouvelable pendant 6 mois », l’ordonnance est valide pour toute la période indiquée. C’est très fréquent pour le suivi de pathologies comme le diabète ou les troubles de la thyroïde.
Note : Veillez à respecter la fréquence indiquée (ex: « tous les 3 mois »).
Les patients en ALD (Affection Longue Durée)
Pour les patients en ALD, les prescriptions sont souvent réalisées sur une ordonnance bizone. Les examens liés à la maladie chronique (partie haute de l’ordonnance) sont couverts à 100 % par l’Assurance Maladie. La validité s’aligne souvent sur la durée du protocole de soins.
FAQ : Questions fréquentes avant d’aller au laboratoire
Puis-je faire une prise de sang sans ordonnance ?
Oui. Vous pouvez demander n’importe quelle analyse sans prescription (test de grossesse, VIH, bilan de santé). Cependant, l’examen sera à votre charge intégrale. Ni la Sécurité Sociale ni votre mutuelle ne vous rembourseront.
Faut-il toujours être à jeun pour une prise de sang ?
Non, cela dépend de l’analyse. La validité de l’ordonnance est une chose, les conditions de prélèvement en sont une autre.
À jeun obligatoire : Glycémie, bilan lipidique (Cholestérol, Triglycérides).
Non obligatoire : Sérologies, coagulation, NFS. [Lien interne suggéré : La liste complète des examens qui nécessitent d’être à jeun]
Dois-je prendre rendez-vous ?
Il est préférable de contacter votre laboratoire, surtout avec une ordonnance ancienne, pour valider le dossier administratif avant de vous déplacer. Pensez à vous munir de votre Carte Vitale et de votre carte de mutuelle à jour.